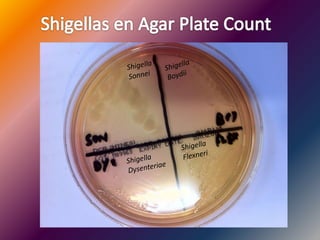

Incrustar presentación
Descargado 24 veces











El documento describe las características de Shigella, una bacteria Gram negativa inmóvil que pertenece al Serogrupo D y causa shigelosis. Shigella fermenta la lactosa lentamente, no forma esporas, es anaerobia facultativa y es muy sensible al pH ácido. Puede producir brotes por alimentos o aguas contaminadas. Las complicaciones incluyen síndrome de Reiter y SHU. Se transmite por la vía fecal-oral directa o indirectamente a través de alimentos o fómites contaminados.